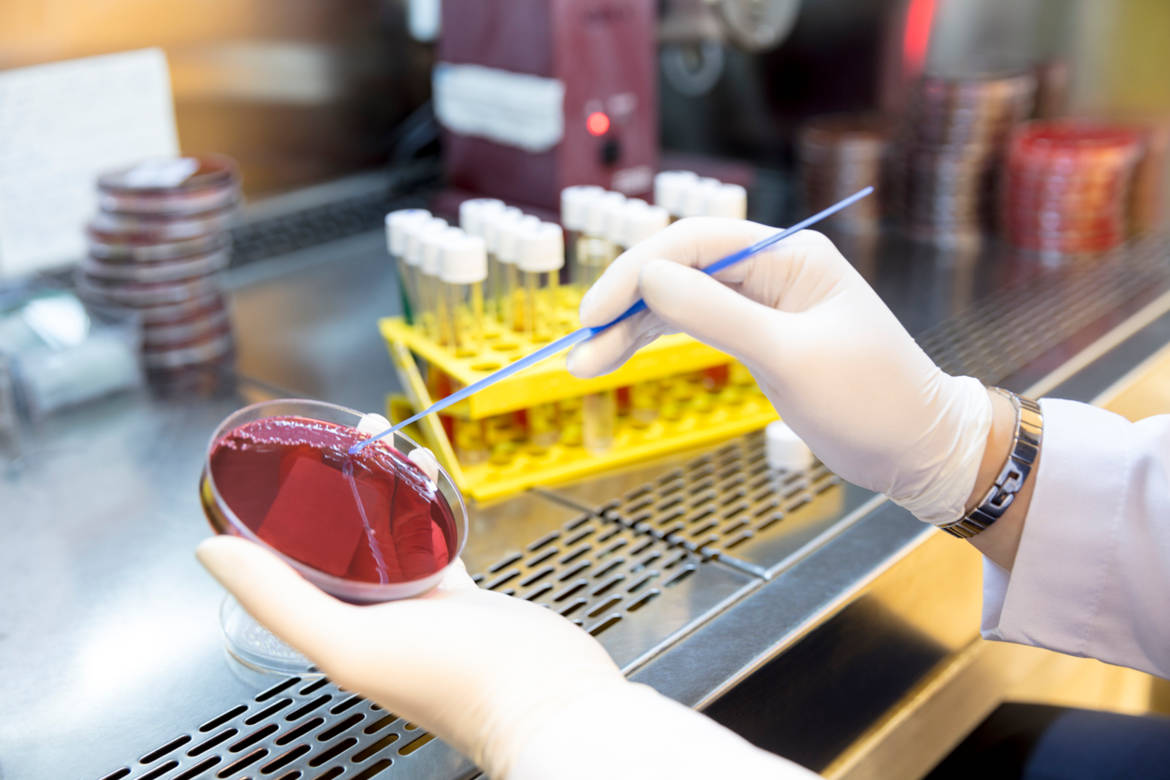

Les antivitamines, une alternative aux antibiotiques
Dernière mise à jour 28/12/20 | Audio
Loading the player ...
© iStock/JazzIRT
La résistance de certaines bactéries aux antibiotiques (l'antibiorésistance) constitue un défi sanitaire majeur selon l'Organisation mondiale de la santé (OMS).
Des scientifiques de lʹUniversité de Göttingen et de lʹInstitut Max Plank, en Allemagne, ont récemment découvert une alternative pour lutter contre la résistance aux antibiotiques: les antivitamines. Qu'est-ce que les antivitamines et comment fonctionnent-elles?
Éléments de réponse avec Gilbert Greub, directeur de lʹInstitut de microbiologie du Centre hospitalier universitaire vaudois (CHUV) au micro de Stéphane Délétroz.
Le laboratoire de Gilbert Greub (CHUV)
La résistance aux antibiotiques (OMS)
Une émission CQFD - RTS La Première
Articles sur le meme sujet

Besoin d’antibiotiques, vraiment?
En Suisse, les efforts déployés pour lutter contre la résistance aux antibiotiques sont certes importants, mais ils demeurent insuffisants face à une problématique qui prend toujours plus d’ampleur. Aperçu des mesures à adopter pour éviter une crise majeure.

Gare aux antibiotiques inutiles
Plus les bactéries sont exposées aux antibiotiques, plus elles sont capables de leur résister. Pour éviter cela, il faut les prescrire avec parcimonie et les consommer en suivant rigoureusement les recommandations médicales. Explications.

Les traitements antibiotiques sont trop longs
Un usage plus restreint des antibiotiques ne diminue pas leur efficacité, selon une étude suisse. Des conclusions importantes dans la lutte mondiale contre l’apparition des résistances.
Videos sur le meme sujet
L'OMS alarme sur la forte propagation des bactéries résistantes aux antibiotiques
Une infection bactérienne sur six résiste désormais aux antibiotiques selon le dernier rapport alarmant de l’OMS.
Un travail de maturité vaudois sur l'antibiorésistance récompensé
Youssef Palma, jeune gymnasien vaudois, reçoit le prix d'excellence de la Société Vaudoise des Sciences Naturelles pour son travail de maturité sur la combinaison de l'antibiothérapie et de la phagothérapie.
"Quand les tendons souffrent de la prise dʹantibiotiques "
Les fluoroquinolones sont des antibiotiques largement consommés en Suisse.




